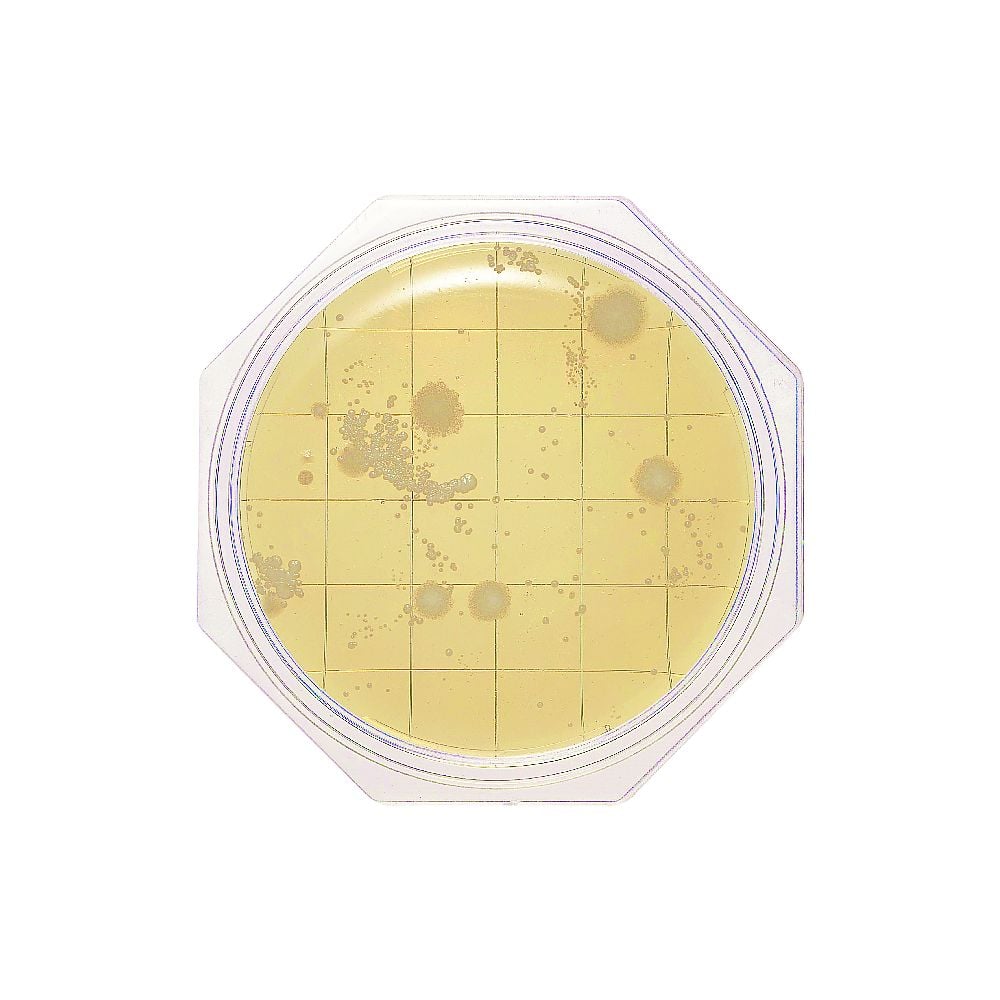
Clean Stamp 25 SCD Agar (for general viable bacteria count measurement) 30 sheets 06791 1 box (3 sheets x 10 bags)

1
/
of
1
島津ダイアグノスティクス
Clean Stamp 25 SCD Agar (for general viable bacteria count measurement) 30 sheets 06791 1 box (3 sheets x 10 bags)
Clean Stamp 25 SCD Agar (for general viable bacteria count measurement) 30 sheets 06791 1 box (3 sheets x 10 bags)
Regular price
¥8,250
Regular price
Sale price
¥8,250
Unit price
/
per
Shipping calculated at checkout.
Couldn't load pickup availability
Japanese Pharmacopoeia Compliant Culture Medium
For environmental microbiology testing
General viable bacteria count medium surface area: 25 cm
Quantity: 30 sheets
Weight: 1020g
*Storage method: 4-10℃ (cannot be frozen)
Expiration date: 12 months after manufacture
View full details